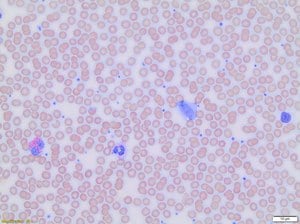
Wright stain modified (manual) 500 ml

Autres réactifs
2143 produits - Trié par pertinence
Cell Navigator Live Cell Endoplasmic Reticulum (ER) StainiµgKit Red Fluorescence 100 Te 100 Tests
Réf. UGAP : 3689920 Réf. constructeur : 22636-AAT
Hematoxylin, mayer's (lillie's modification) 500 ml
Réf. UGAP : 3721514 Réf. constructeur : ZUC087-500